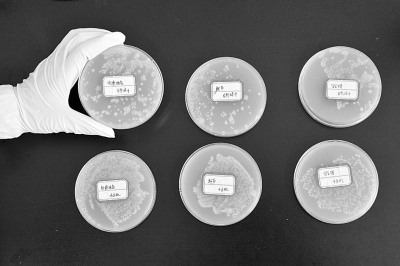
n_070401

上排为自然晾干的手上细菌含量,下排为干手机烘干的手上细菌含量。
记者分别采集三组样本做实验,结果证实
干手机烘手确实越烘越脏
近日,一则“用干手机烘干手=白洗”的微博在网上热传,短短几天阅读量超过24万,转播千余次。微博称,公共场所的干手机不用直接接触,给人感觉很卫生,实则不然。这是因为干手机一般安装在洗手池附近,温暖潮湿的环境会加速内部细菌增长,干手时反而把手吹脏了。
话题一出,迅速引起网友热议。有人认为,专家标准接近洁癖,对普通人没有借鉴价值。有人表示信息不可信,电热丝产生的高温环境,应该不适合细菌的生存繁殖。也有人提出质疑,说法没有实验数据支撑,真实性有待考证。
干手机真的会把手吹脏吗?6月29日—7月1日,记者在武汉市结核病防治所检验科专家的帮助下,做实验求证。
烘干的手上细菌含量高出一倍
6月29日上午,记者分别在解放大道国际广场六楼、麦当劳餐厅和航空路新世界A栋19层洗手间取样。具体做法为,先用自来水洗手15秒,为了比对效果,左手用干手机烘干,右手自然晾干。然后用一次性拭子采样器在手心擦拭,接种于无菌的营养琼脂培养基上。实验提取到三组共6份样本,两小时内置入恒温37℃的细菌培养箱。
经过24小时细菌培养,培养皿中白色菌群渐渐清晰。记者昨在市结防所微生物实验室看到,用写字楼、商场和快餐厅干手机吹干的左手,菌群数量分别为206个、261个和316个;自然晾干的右手,菌群数量分别为91个、107个和163个。结果证实,干手机确实把手吹脏了,其中快餐店干手机造成的二次污染,超过写字楼和百货商场。
市结防所检验科副主任技师任易介绍,干手机的工作原理是,当红外线感应到双手靠近,风机自动运转,将周围环境中的空气吸进去加热,然后再加压吹出来。由于公共卫生间本身属于多菌环境,而干手机出风口60℃左右的温度不能有效杀菌,反而加速空气流动,把更多环境细菌吹到了手上。
另据果壳网一篇文章介绍,英国布拉福德大学曾做类似实验,对干手机和纸巾擦手进行对比,结果显示,纸巾能够擦掉皮肤表面一半的细菌,比干手器更有效。
手部细菌主要是大肠杆菌
实验中,记者在写字楼洗手后,右手自然晾干,检出菌群数量90个左右,为本组数据最低值。即便如此,专家仍直言不讳:太脏了!
任易介绍,为了防止医院内部感染,医护人员每次洗手最少半分钟,手上细菌数最多两三个,就算普通市民,洗手后细菌总数也应在50个以内。
那么,为什么记者洗过的手仍然这么脏呢?他分析,首先可以确定洗手方式不科学,也没有使用洗手液或肥皂,手部清洁不彻底。其次,由于压力因素,自来水公司输送的水一般只能到达4楼,更高的楼层,要靠水箱或泵房加压后向上输送。如果设备和管道没有经常更新或清洁,自来水质量就可能受到影响。不排除记者洗手用水的清洁度,对实验结果产生干扰。
任易说,在记者手部检出的细菌,以大肠杆菌和表皮白色葡萄球菌为主,会引起急性腹泻和泌尿系统感染,葡萄球菌侵袭机体还可引起肺炎、脑膜炎、心内膜炎甚至败血症。如果用污染的手拿食物吃,或触摸鼻子、眼睑等,就相当于敞开城门,放任细菌涌入体内。
“六步洗手法”
可清除99%的细菌
协和医院感染性疾病科主任揭盛华介绍,一只手可以沾染4万—40万个细菌,指甲缝最容易藏污纳垢,可以藏纳38亿个细菌。用流水洗手,可洗去手上80%的细菌,用肥皂洗则可洗去99%的细菌。
市防所主任医师袁保东介绍,医护人员严格按照"六步洗手法"清洁,手部细菌可控制在5个菌群以内,这套方法同样适用于普通市民。
第一步,湿润双手涂抹洗手液或肥皂,掌心相对,手指并拢互相揉搓;
第二步,手心对手背沿指缝相互揉搓,两手交换进行;
第三步,掌心相对,双手交叉沿指缝相互揉搓;
第四步,半握拳放在另一手掌心旋转揉搓,两手交换进行;
第五步,一手握另一手大拇指旋转揉搓,两手交换进行;
第六步,搓洗手腕和手臂,交换进行。